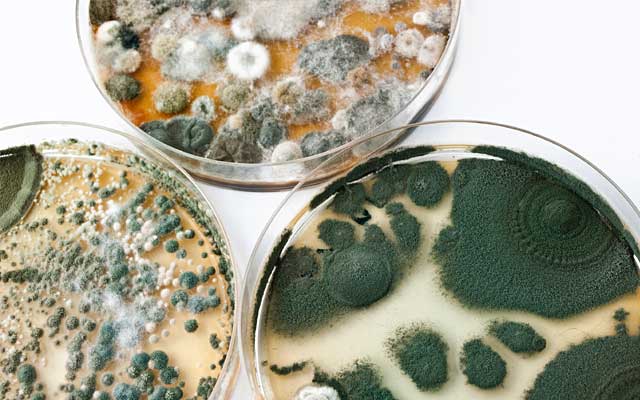

Unsere Kernleistungen
Unten stehend haben Sie eine Kurzübersicht über die von uns abgedeckten Kernleistungen. Für detailliertere Informationen verweisen wir auf den Menüpunkt "Leistungen".
Baubegleitung:
- vom Rohbau bis zur Erstellung
- (baubegleitende) Qualitätssicherung
- Schadensprävention
- Bauleitung
- Bauleistungskontrolle
- Ausschreibungsprüfung
- Vertragsprüfung
- Baudokumentation
- Bauprüfung
- Bauabnahme
- Wohnflächenüberprüfung -/ Kontrolle
- Hauskauf / Haus-Check
- Wohnungsübergaben
mehr unter LEISTUNGEN
Schadengutachten:
Energieberatung:
- Gebäudeenergieberatung
- Sanierungskonzepte
- Qualitätssicherung
- Erstellung von Energieausweisen
- Rentabilitätsberechnungen
- Taupunktberechnung
- Bauteilüberprüfungen
- KfW- Fördermittelbeantragung
- Hauskauf / Haus-Check
- Gebäudebewertung
- Thermografie
mehr unter LEISTUNGEN